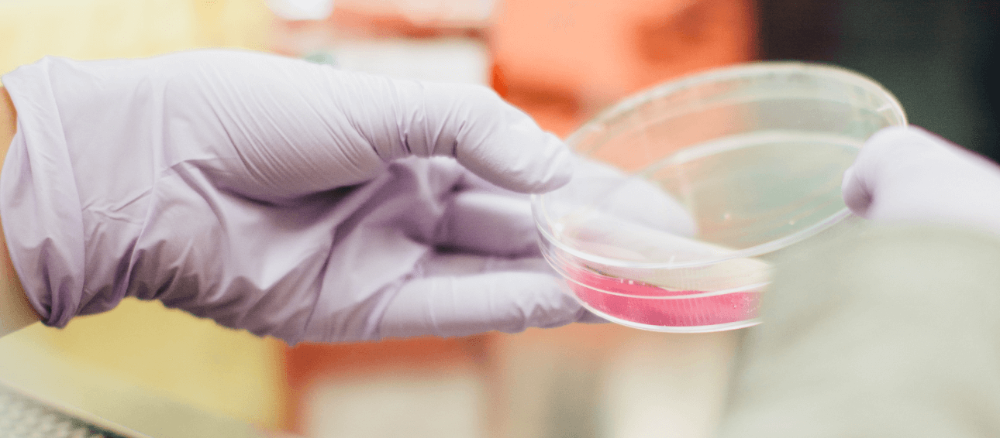
Carrera acreditada por 2 años hasta noviembre de 2020, impartida en Santiago, en jornada diurna y modalidad presencial. Comisión Nacional de Acreditación.

Pedagogía en Educación Media en Biología y Química
- Grado Académico
- Licenciado/a en Ciencias Naturales
Licenciado/a en Educación Media con mención en Ciencias Naturales
- Título profesional
- Profesor/a de Educación Media en Biología y Química
- Nº de Decreto
- D.U. N.º 0033908 del 26 de agosto de 2014, modificado por D.U. N°0016478 de 2020
- Facultad o Instituto
- Facultad de Ciencias
- Duración
- 10 semestres académicos, jornada diurna, currículum semiflexible
El propósito del programa académico es formar profesores de Biología y Química con una sólida formación básica en su especialidad, que les permita comprender los fenómenos naturales y tecnológicos desde una perspectiva que integra las dos disciplinas. La formación tanto disciplinar como pedagógico-didáctica permitirá realizar una docencia que relacione los conocimientos científicos con el medio que les rodea, empleando diversos recursos educacionales, así como haciendo uso de metodologías acordes con las nuevas visiones de la enseñanza de la ciencia. Además, el Programa propone entregar una formación profesional que integre al profesor al mundo globalizado, de manera que pueda reconocer la diversidad en sus estudiantes y tenga la autonomía suficiente para adaptar el proceso de enseñanza-aprendizaje a la realidad del aula en que se encuentre, como a las directrices indicadas en el currículo escolar.
Campo Laboral: Los titulados de esta carrera podrán desempeñarse como docentes de la especialidad en instituciones de educación públicas y privadas. Podrán participar en investigación en áreas de la Educación y estarán capacitados para realizar estudios de posgrado en las áreas disciplinarias o pedagógico-didácticos.
Esta carrera se imparte en conjunto por la Facultad de Ciencias y la Facultad de Filosofía y Humanidades. La primera entrega la formación en las disciplinas científicas y la segunda entrega la formación pedagógica y didáctica específica.
Admisión
Proceso de Admisión Regular 2026:
| Código de postulación: | 11521 | |||
| Vacantes 2026: | 50 | |||
| Revisa los requisitos generales de postulación a la Universidad de Chile y los requisitos específicos para carreras de Pedagogía. | ||||
Requisitos y ponderaciones Admisión 2026:
| Notas de Enseñanza Media | 10% |
| Ránking de Notas | 20% |
| Prueba PAES de Competencia Lectora | 20% |
| Prueba PAES de Competencia Matemática 1 | 15% |
| Prueba PAES de Competencia Matemática 2 | 10% |
| Prueba PAES de Ciencias | 25% |
Procesos de Admisión Especial 2026:
| Vacantes BEA (ver más) | 5 |
| Vacantes SIPEE (ver más) | 1 |
| Vacantes PACE (ver más) | 2 |
| Vacantes Ed. Media en el Extranjero (ver más) | 3 |
| Vacantes para Deportistas Destacados/as (ver más) | 2 |
| Vacantes para Est. de Pueblos Indígenas (ver más) | 3 |
| Vacantes para Est. Sit. de Discapacidad (ver más) | 2 |
| Vacantes Equidad de Género (ver más) | 5 |
| Vacantes Cupos Explora-UNESCO (ver más) | 2 |
Acreditación
Carrera acreditada por 4 años, desde abril de 2022 hasta abril de 2026, por la Comisión Nacional de Acreditación. Impartida en Santiago, en jornada diurna y modalidad presencial. Institución acreditada por 7 años.
Perfil de egreso
El/La Profesor/a en Educación Media en Biología y Química de la Universidad de Chile es un/a profesional que ejerce su labor docente sustentado/a en una sólida formación disciplinar y profesional para favorecer la comprensión de la naturaleza de los fenómenos biológicos y químicos de la vida cotidiana. Diseña e implementa estrategias de enseñanza y evaluación para el aprendizaje, favoreciendo el desarrollo integral del/de la estudiante, considerando la diversidad y los distintos contextos socioculturales y comunidades educativas. Su formación abarca los ámbitos académicos de la pedagogía y la didáctica, las ciencias naturales, un ámbito profesional de investigación reflexiva en la práctica y un ámbito ético-valórico. Es capaz de trabajar colaborativamente, investigar, reflexionar y tomar decisiones sobre su quehacer profesional pedagógico, generando conocimiento sobre el proceso de enseñanza y aprendizaje de las ciencias naturales, enfatizando el respeto y cuidado de la diversidad, los seres vivos y el medio ambiente. El/La titulado/a de la carrera de Pedagogía en Educación Media en Biología y Química es un/a profesional con vocación de excelencia, actualizado/a en los conocimientos científicos y profesionales y atento/a a las necesidades de su comunidad. Su formación desarrolla una mirada ética, crítica y autocrítica, que es coherente con los principios orientadores de la Universidad de Chile, pues fortalece la equidad, aporta a la inclusión y valora la diversidad.
Plan de formación
Nota: Los planes de formación podrán ser modificados en función del mejoramiento continuo de la carrera. La columna "SCT" (Sistema Créditos Transferibles) expresa el trabajo académico realizado por el estudiante en el periodo correspondiente. La columna "Sem." se refiere al semestre en que el alumno puede tomar la asignatura en primera oportunidad, siempre que cumpla con los requisitos. La columna “Ámbito” , representan los ámbitos de realización del futuro Profesor/a, son 4: Ámbito Ciencias Naturales, Ámbito Pedagogía y Didáctica, Ámbito Investigación reflexiva en la práctica y Ámbito Ético-Valórico.
| ACTIVIDAD CURRICULAR |
ÁMBITO
|
SCT
|
Sem.
|
Primer Semestre |
|||
| Matemáticas I |
Ciencias Naturales
|
8
|
I
|
| Química general I |
Ciencias Naturales
|
8
|
I
|
| Ciencia cotidiana |
Ciencias Naturales
|
5
|
I
|
| Fundamentos de la Educación y la Pedagogía |
Pedagogía y Didáctica
|
5
|
I
|
| Comunicación Oral y Escrita |
|
2
|
I
|
Segundo Semestre |
|||
| Matemáticas II |
Ciencias Naturales
|
8
|
II
|
| Química general II |
Ciencias Naturales
|
8
|
II
|
| Biología celular |
Ciencias Naturales
|
8
|
II
|
| Taller de investigación y práctica I: Identidad Docente |
Pedagogía y Didáctica
|
3
|
II
|
| Procesos psicológicos del aprendizaje |
Pedagogía y Didáctica
|
5
|
II
|
Tercer Semestre |
|||
| Física I (introducción a la mecánica) |
Ciencias Naturales
|
8
|
III
|
| Química inorgánica |
Ciencias Naturales
|
8
|
III
|
| Química orgánica I |
Ciencias Naturales
|
8
|
III
|
| Diversidad e Inclusión en el aprendizaje de la especialidad |
Pedagogía y Didáctica
|
5
|
III
|
Cuarto Semestre |
|||
| Física II (electromagnetismo y óptica) |
Ciencias Naturales
|
8
|
IV
|
| Zoología sistemática y funcional |
Ciencias Naturales
|
7
|
IV
|
| Botánica sistemática y funcional |
Ciencias Naturales
|
7
|
IV
|
| Taller de investigación y práctica II: Sujeto que aprende |
Pedagogía y Didáctica
|
4
|
IV
|
| Sujeto joven y culturas juveniles |
Pedagogía y Didáctica
|
3
|
IV
|
| CFG 1 |
|
2
|
IV
|
Quinto Semestre |
|||
| Fisicoquímica I |
Ciencias Naturales
|
6
|
V
|
| Química orgánica II |
Ciencias Naturales
|
8
|
V
|
| Bioquímica |
Ciencias Naturales
|
8
|
V
|
| Desarrollo del currículum |
Pedagogía y Didáctica
|
5
|
V
|
| Inglés I |
|
3
|
V
|
Sexto Semestre |
|||
| Fisicoquímica II |
Ciencias Naturales
|
6
|
VI
|
| Ecología |
Ciencias Naturales
|
7
|
VI
|
| Fundamentos de la Didáctica de las Ciencias Naturales y Práctica Pedagógica. |
Pedagogía y Didáctica
|
5
|
VI
|
| Taller de investigación y práctica III: Comunidades educativas |
Pedagogía y Didáctica
|
4
|
VI
|
| Comprensión histórica y sociológica de la escuela y la educación |
Pedagogía y Didáctica
|
5
|
VI
|
| Inglés II |
|
3
|
VI
|
Séptimo Semestre |
|||
| Estadística aplicada a las ciencias |
Ciencias Naturales
|
5
|
VII
|
| Microbiología |
Ciencias Naturales
|
7
|
VII
|
| Genética y evolución biológica |
Ciencias Naturales
|
7
|
VII
|
| Diseños Didácticos en Ciencias Naturales y Práctica Pedagógica |
Pedagogía y Didáctica
|
4
|
VII
|
| Evaluación para el Aprendizaje |
Pedagogía y Didáctica
|
5
|
VII
|
| Liderazgo pedagógico y estrategias colaborativas |
Pedagogía y Didáctica
|
3
|
VII
|
Octavo Semestre |
|||
| Anatomía y fisiología comparada |
Ciencias Naturales
|
9
|
VIII
|
| Didáctica de la Biología y Práctica Pedagógica |
Investigación reflexiva en la práctica
|
4
|
VIII
|
| Didáctica de la Química y Práctica Pedagógica |
Investigación reflexiva en la práctica
|
4
|
VIII
|
| Taller de investigación y práctica IV: Las relaciones pedagógicas |
Investigación reflexiva en la práctica
|
4
|
VIII
|
| Seminario de Grado en Ciencias Naturales |
Ciencias Naturales
|
5
|
VIII
|
| Inglés III |
|
3
|
VIII
|
Noveno Semestre |
|||
| Didáctica de la Biología y Práctica Profesional |
Investigación reflexiva en la práctica
|
6
|
IX
|
| Didáctica de la Química y Práctica Profesional |
Investigación reflexiva en la práctica
|
6
|
IX
|
| Taller de investigación y práctica profesional I. Jefatura de Curso |
Investigación reflexiva en la práctica
|
8
|
IX
|
| Investigación en Educación |
Investigación reflexiva en la práctica
|
3
|
IX
|
| Electivo de Profundización |
|
5
|
IX
|
| CFG 2 |
|
2
|
IX
|
Décimo Semestre |
|||
| Proyecto Integrado de las Ciencias Naturales y Práctica Profesional |
Investigación reflexiva en la práctica
|
12
|
X
|
| Taller de investigación y práctica profesional II. Jefatura de Curso y proyecto institucional |
Investigación reflexiva en la práctica
|
8
|
X
|
| Ética y Ciudadanía |
Investigación reflexiva en la práctica
|
2
|
X
|
| Seminario de Grado en Educación |
Investigación reflexiva en la práctica
|
5
|
X
|
| Inglés IV |
|
3
|
X
|
Departamento de Pregrado
Vicerrectoría de Asuntos Académicos